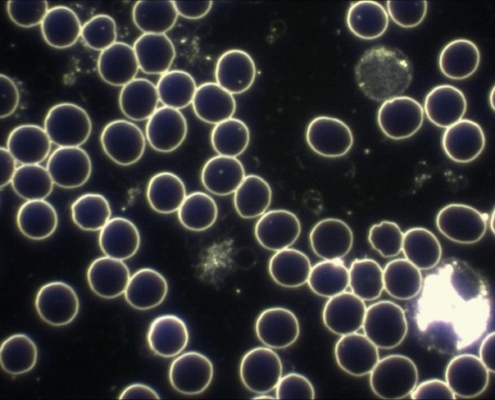

Wer wird von Bill Gates finanziert? Glauben Sie, dass diese Verlage und Institutionen „unabhängig“ sind?
Wenn man Milliardär ist, dann hat man viel Geld. Wenn man viel Geld hat, dann kann man damit viel machen, bewegen, veranlassen etc. Es kommt halt darauf an, WAS man damit macht.
Im Fall von Bill Gates war ich mir da nie sicher. Seit Corona…

Robert Kennedy über Bill Gates und dessen Impfprogramme und „Menschenversuche“ in Indien
Robert Kennedy Jr. ist der Sohn von Robert Kennedy Senior, der Ende der 1960er Jahre ermordet wurde. Er ist Rechtsanwalt von Beruf und setzt sich aktiv für Umweltfragen ein, sowie für eine exakte und vorurteilsfreie Betrachtung und Beurteilung…

Corona-Sterblichkeit überschätzt – Die Bundesregierung und ihr „Corona-Aktionismus“
John Ioannidis[1] ist ein Professor für Medizin, Gesundheitsforschung und biomedizinische Daten an der Stanford Universität in den USA.
Als solcher hatte er bereits im März[2] einen bemerkenswerten Artikel veröffentlicht, der mit der Überschrift…

SPD gegen Homöopathie – Mann muss sich mal anschauen, was der Parteitag beschlossen hat!
Seit es die Homöopathie gibt, gibt es sogenannte "wissenschaftliche Skeptiker", die die Homöopathie als Therapie verbieten wollen. Die Diskussion wurde bis vor wenigen Jahren im Wesentlichen "nur" in Fachkreisen ausgetragen. Aber seit ca.…

Die Schweinegrippe 2009 – Der Skandal danach
Die WHO hatte die Schweinegrippe im Jahr 2009 zur weltweiten Katastrophe erklärt. Und es war ziemlich schnell klar: Man kann sich dem (angeblich) sicheren Tod nur entziehen, wenn man auf die Produkte der Industrie zurückgreift:
Impfung…
Das hier ist das beste Medikament gegen jeden Virus…
Ich will es gar nicht so spannend machen: Das beste Medikament gegen jeden Virus ist das eigene Immunsystem, genauer gesagt die Lymphozyten.
Hier eine Aufnahme aus einem Dunkelfeldmikroskop von "lebendem" Blut:
Wie man die Dunkelfeldmikroskopie…

Mehr Tote durch Anti-Corona-Maßnahmen als durch COVID-19?
Seit zwei Wochen werden wir von den "offiziellen Medien", sowie in Pressekonferenzen Tag für Tag, Stunde für Stunde belehrt, als dass Covid-19 "sehr ernst zu nehmen sei".
Dabei wird durch Zahlen und entsprechende Stellungnahmen auch suggeriert,…

Von der Schweinegrippe bis Corona: Die Profiteure der Angst
"Die Profiteure der Angst" - Ich kann nur dazu raten, sich mal folgende Dokumentation des ARTE Senders aus dem Jahr 2009 anzusehen:
https://www.youtube.com/watch?v=kKkQH6JO4n8
Ein Blick in die Geschichte lohnt sich!
Zu sehen sind dort auch…

Schweizer Kanton Genf verbietet den Bau von 5G – dennoch: bühnenreife Tricks der Schweizer Mobilfunk-Industrie
Was ich letztes Jahr noch nicht für möglich hielt: Es wird endlich über die Auswirkungen der 5G Mobilfunktechnologie diskutiert!
Im ersten Beitrag (August 2018) schrieb ich noch: 5G Mobilfunk - Alle jubeln, aber kaum jemand weiß wirklich…

Wie bitte? Robert-Koch-Institut: Präsident Wieler sagt „Es gibt keinen Erreger“
Das Robert-Koch-Institut gibt in regelmäßigen Abständen Lageberichte zu COVID-19 heraus. Der Lagebericht vom 13. März 2020, den es auch noch auf YouTube zu sehen gibt, enthält eine mehr als merkwürdige, geradezu verstörende Aussage des…
Wer schreibt hier?

Ich begleite seit 1998 Patienten in meiner Naturheilpraxis auf ihrem Weg zu mehr Gesundheit und Wohlbefinden. Meine eigene Reise begann 1996, als ich nach einer schweren Erkrankung die Schulmedizin hinter mir ließ. Diese Herausforderung brachte mich zur Naturheilkunde, die nicht nur meine Gesundheit wiederherstellte, sondern auch mein Verständnis von ganzheitlicher Heilung für immer veränderte.
Dieser Blog ist mein persönlicher Raum, um Erfahrungen, praktische Tipps und Erkenntnisse aus der Naturheilkunde und Alternativmedizin mit Ihnen zu teilen. Mein Ziel ist es, die Möglichkeiten dieser Ansätze verständlich und greifbar zu machen – für Ihre Gesundheit und Ihr Leben.
Stellen Sie Ihre Fragen in den Foren!
Schlagwörter
5G
Arzneimittel
Cholesterin
Cola
Corona
Covid-19
Entgiftung
Ernährung
Gates
Genetik
Genfood
Genmais
Gentechnik
Gesundheit
Gift
Glyphosat
Grippe
Grippeschutzimpfung
Heilung
Homöopathie
Impfung
Impfungen
Kinder
Kinderrechte
Konzerne
Krankenkassen
Krebs
Medikamente
Merkel
MESZ
Mobilfunk
Monsanto
Nanotechnologie
PCR-Tests
Pharmakartell
Politik
Schulmedizin
Schweinegrippe
Sommerzeit
Studien
Umweltschutz
WHO
Wissenschaft
Zeitumstellung
Zucker









